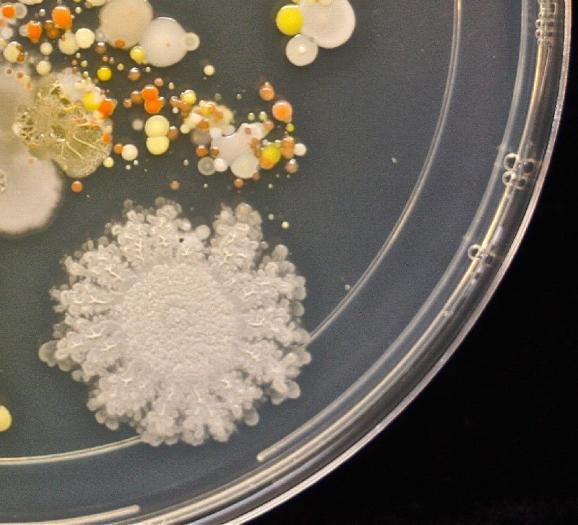

Мікробіолог зробила мікробний відбиток руку дитини. Кількість бактерій на долоні вражає.
Про це повідомляє Еспресо.TV з посиланням на Business Insider.
Усіх дітлахів з самого дитинства привчають мити руки з милом, лякаючи страшними бактеріями та хворобами. Але теоретична можливість потрапити до шпиталю часто не лякає малюків.
А якщо б можна було почати з цих потворних мешканців немитих рук?
Мікробіолог з США Таша Стурм "зняла" мікробний відбиток з руки свого восьмирічного сина. Слід долоні був залишений у чашці Петрі, де, як відомо, науковці та лаборанти культивують бактерії.
Потім посудину протримали добу у спеціальному інкубаторі при температурі 37 градусів Цельсія, а потім ще кілька днів - у приміщенні з кімнатною температурою.
Результати дослідження "квітнуть на пахнуть".
Фото: Tasha Sturm at Cabrillo College via MicrobeWorld